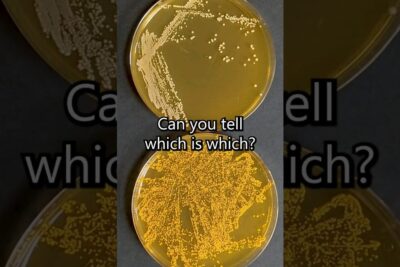
Two petri dishes with yellow bacterial colonies on agar showing distinct colony patterns and densities genmodifiserte organismer 2

Fordeler og ulemper med internett: Utforsk begge sider av mynten
Fordeler og ulemper med internett: Utforsk begge sider av mynten
Nødvendighet: For eller mot behovet
Legalisering av prostitusjon: Argumenter for og imot

Fordeler og ulemper ved en sentralamerikansk føderasjon: En grundig oversikt
Utforsk fordeler og ulemper ved en sentralamerikansk føderasjon Oppdag potensialet for økt samarbeid og stabilitet i regionen!
Leer más
Piratkopiering: Fordeler og ulemper ved digital piratkopiering
Oppdag fordelene og ulempene ved digital piratkopiering! Påvirkning på økonomien, kunstnere og forbrukere. Klikk her! ☠️
Leer más
Fordeler og ulemper med bruk av genmodifiserte organismer
Oppdag de kontroversielle fordelene og ulemperne ved å bruke genmodifiserte organismer i landbruket. Få innsikt og ta et informert valg! →
Leer más
Fordeler og ulemper med WTO: En grundig analyse av verdens handelsorganisasjon
Fordeler og ulemper med WTO Oppdag hvordan verdens handelsorganisasjon påvirker økonomier og handel globalt! Klikk her nå!
Leer más
Var fortiden virkelig bedre? En debatt om nostalgiens makt
️Undrer du deg over om fortiden virkelig var bedre? Utforsk kraften til nostalgi i denne spennende debatten. Klikk her for å finne ut mer!
Leer más
Lov mot familie- og hjemmevold: Beskyttelse av de sårbare
Hold dine kjære trygge og beskyttet! Les vår engasjerende artikkel om loven mot familie- og hjemmevold. Finn ut hvordan vi kan stå sammen og beskytte de sårbare. Klikk her!
Leer más
Teknologi: Etisk dilemma eller fremtidens løsning?
Bli med på en reise gjennom teknologiens etiske dilemmaer og oppdag hvordan det kan være nøkkelen til fremtiden! Les mer her!
Leer más
Folkejury: For eller imot?
Bli med i debatten! Utforsk fordeler og ulemper ved folkejuryen i Norge. Er du for eller imot? Les mer og bli overrasket! #folkejury #norge
Leer más
Argumenter for og mot positiv diskriminering: En grundig analyse
Bli med på en grundig analyse av argumentene for og mot positiv diskriminering! Utforsk synspunktene og utfordre dine meninger. Klikk her! ✨
Leer más